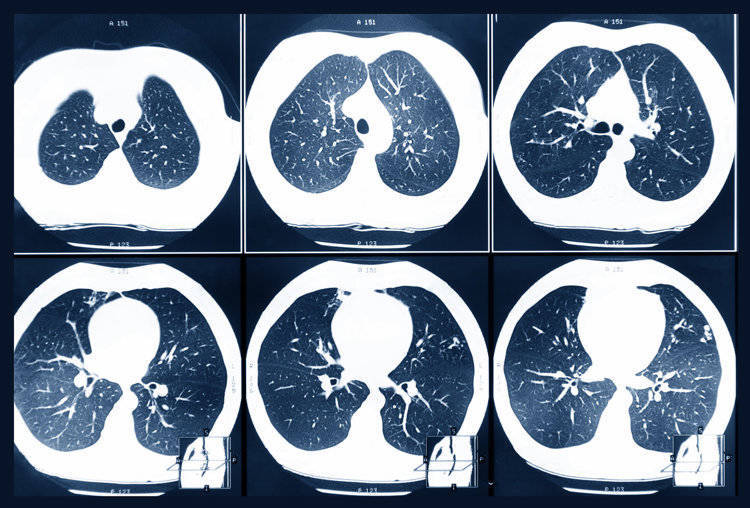

刘先生今年49岁,在去年的体检中查出肺部存在5mm的磨玻璃结节,医生建议3个月复查一次。但刘先生工作很忙,加上觉得身体没有不适症状,就没太当回事,自然也没去复查。
今年年初,他身上出现了明显的咳嗽症状,严重时还会带有血丝。平躺时还会明显感觉胸口发闷,稍微爬几层楼梯就得停下来休息。这让他察觉情况不对,联想到去年的体检,怀疑是结节恶化了。
第二天就请假去了医院检查,结果发现结节已经增长到了14mm,且出现了实性成分。后续的增强CT、肿瘤标志物检查高度怀疑是恶性肿瘤,刘先生被安排入院进行相关治疗。好在刘先生的病程还处于早期,可以进行手术治疗,术后他很快就康复出院了。

但并不是所有人都像刘先生这么幸运,不少患者确诊时就处于中晚期,失去了手术治疗的机会,令人十分惋惜。
一、为什么现在得肺结节得人越来越多?
广州呼吸健康研究院院长何建行教授表示,我国体检筛查出的肺结节人群约有1.2~1.5亿,通过数据不难看出肺结节是个十分多见的问题。
为什么现在会有这么多的肺结节患者呢?与多个因素相关。
首先,现在的医学影像技术越来越发达,检查时的分辨率较高,一些隐匿性、之前难以发现的病灶也可以及时发现,这样一来检出结节的几率自然也会增加。

其次,人长期处于自然环境下,难免需要接触细菌、病毒感染以及大气污染等问题,这些均会增加肺部组织受损,罹患肺结节的风险。而且随着年龄增加,体内各器官老化,也更容易出现肺部疾病,其中就包括肺结节。
此外,现在多数人都长期缺乏运动、熬夜、吸烟酗酒,这些不良生活习惯也会让身体免疫力下降,也有可能促进肺结节的发生。
从中医角度来看,肺结节的出现与脾虚痰湿、肝气郁结等因素相关,可以说与五脏六腑都有关系。如一个人脾虚的话,会导致体内水湿无法正常运化,而肺是体内贮痰的脏器,大量痰液积聚在肺部,会导致结节生成。还有就是长期情绪不良、闷闷不乐,会让肝气郁结,影响肺气肃降,从而增加肺结节的发生风险。

二、出现这些症状时,应警惕肺结节
体内出现肺结节后,身体可能会出现一些不适症状,这几个症状出现要及时就医。
1、咳嗽老不好
肺部出现结节可能会刺激气道引起炎症,进而引起持续性干咳、咳痰等症状,如若结节累及到胸膜的话,还可能伴有胸痛症状。
2、胸痛胸闷
结节出现在胸膜附近,可能会压迫到周围的组织,诱发胸部隐痛、刺痛症状。在深呼吸、咳嗽以及运动时,症状会更为明显。

3、乏力出虚汗
罹患肺结节可能会导致疲惫、睡梦中盗汗的症状,出现该症状建议及时就医排查相关病症。
4、喘不上气
肺部内出现异常病灶会压迫到正常组织,可能会引起呼吸急促的症状,表现为喘不上气。
很多患者在罹患肺结节后,身体没有任何不适症状,这种情况下只能通过胸部CT检查来发现结节。

三、肺结节就是肺癌?先别焦虑!
当胸部CT检查普遍后,很多人会被检查结果上的肺结节结果吓到,担心结节会发生癌变。在我国第31个全国肿瘤防治宣传周上,中国抗癌协会整合肿瘤分会青委会主委薛建新明确指出,体检中查出的肺结节95%为良性,只有5%有恶变的可能性。
有这几种特征的肺结节,恶性程度很高,要多加警惕:
• 大小:体积越大的结节危险程度就越高
• 数量:相同性质的结节,数量越多的恶性程度会比数量少的要高
• 长相:结节有毛刺征、分叶状、血管集束征、胸膜凹陷征等特征,恶性程度较高
• 位置:处于肺叶处的结节风险性较高,中下肺叶的则危险程度较低
• 变化:在发现结节后,医生会建议定期进行复查,复查过程中发现结节变大或是形态发生了改变,都要警惕可能是恶变了
• 密度:从危险程度上来看,是混合型>磨玻璃>实性

除了恶性结节有一定的特征外,良性结节也有自己的特点。如果你的结节有这几种表现的话,基本上可以排除肺癌的可能性。
1、完全钙化的结节
很多肺部疾病会以钙化为最终结局,尤其是感染性的疾病,痊愈后可能会形成疤痕或钙化灶。完全钙化的结节基本没有活性了,不会变大也不会变小,自然也不会癌变。

2、发生位置移动的结节
一般情况下,恶性结节会在固定的位置不断变大,不会发生转移。如果结节发生转移的话,说明内部以液体、活动性成分为主,这样的结节基本不可能是恶性的。
3、长得过快的结节
大部分肺癌的生长过程是很缓慢的,不会缩小也不会突然变大很多。但如果是新鲜炎症所致的结节,有时候会在一个星期内增长一倍大小,这种情况基本就可以排除恶性了。
查出肺结节后不必过于担心,但一定要遵医嘱定期进行复查,复查可及时发现结节的变化,如有恶变倾向也能及时作出处理。
参考资料:
[1] 中华医学会呼吸病学分会肺癌学组,中国肺癌防治联盟专家组. 肺结节诊治中国专家共识(2018年版)[J]. 中华结核和呼吸杂志,2018,41(10):763-771. DOI:10.3760/cma.j.issn.1001-0939.2018.10.004.
[2] 《网友:体检查出肺结节怎么办?医生:别担心,90%的肺结节不是癌症……》.人卫健康2025-02-21
[3] 《查出肺结节先别慌!出现这几个表现,基本就是良性的》.中国医学论坛报2025-12-29
未经作者允许授权,禁止转载
长胜配资提示:文章来自网络,不代表本站观点。